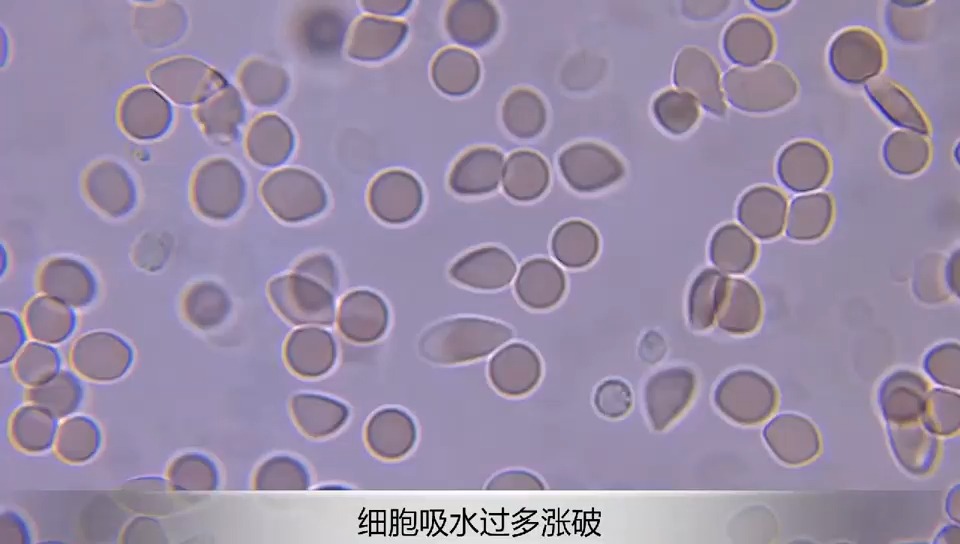
小金蛙红细胞

红细胞吸水失水

红细胞吸水和失水
图片尺寸1024x683
失水皱缩的红细胞吸水复原过程
图片尺寸448x336
被动运输
图片尺寸1088x608
微观视角下,红细胞失水皱缩瞬间
图片尺寸1080x675
< 细胞质浓度:细胞吸水膨胀,若膨胀过度,细胞膜会被胀破,红细胞将死亡
图片尺寸1080x1292
红细胞吸水涨破
图片尺寸1080x1439
1物质的跨膜运输实例5.2ppt
图片尺寸1080x810
红细胞失水后的微观变化
图片尺寸720x960
关于动物细胞吸水涨破实验的思考
图片尺寸720x535
高中生物苏教版必修一第三章第二节细胞的类型和结构课件21张
图片尺寸860x645
小金蛙红细胞
图片尺寸960x544
⭕️二,先见红后破水 见红是临产前一个信号,红色或粉色
图片尺寸1920x2560
淡水鱼能在海中存活吗?黄河中的鱼被冲进大海之后,究竟怎样了?
图片尺寸1193x672
实验:植物细胞的吸水和失水.#显微镜的使用方法 #质壁分离及
图片尺寸2880x2160
二,动物细胞的吸水和失水 细胞质溶液 外界溶液 清水 盐水 0
图片尺寸1440x810
当将红细胞放在清水中细胞会 吸水胀破 再用差速离心法就可得到较纯的
图片尺寸1080x810
生物:3《细胞的基本结构》hao课件
图片尺寸1080x810
被动运输
图片尺寸1088x608
现象:细胞膨胀 原因:外界溶液浓度 小于 细胞质的浓度,细胞 吸水
图片尺寸1080x810
河北石家庄市20192020学年第二学期高二生物一轮复习红细胞专题16张
图片尺寸720x540